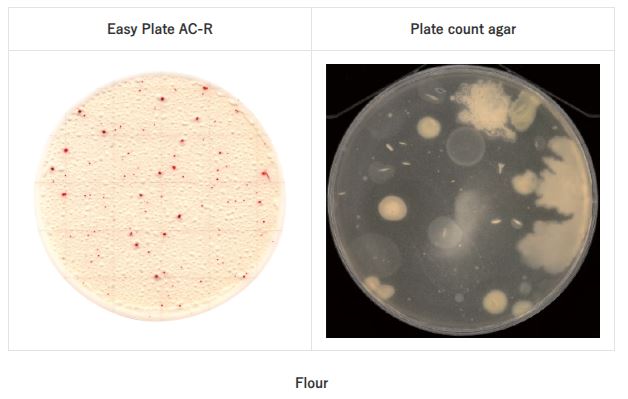
Colonies in Easy Plate AC-R
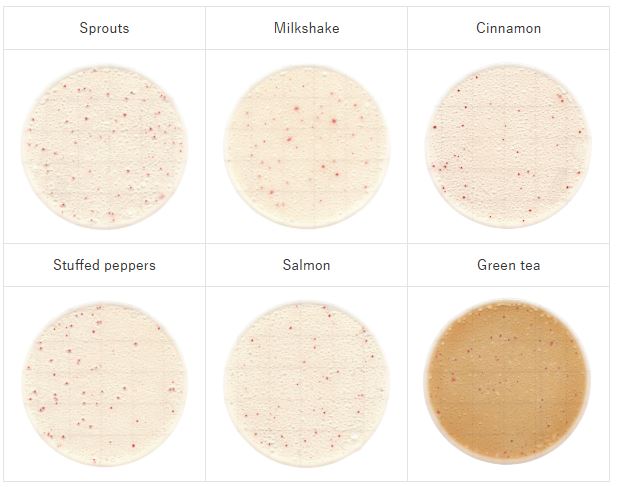
Foods in Easy Plate AC-R

Prepared media plate for Aerobic Bacteria count (Rapid Type ) | Easy Plate AC-R Kikkoman
1. Introduction to Easy Plate
- Easy Plate is a convenient ready-to-use culture plate that requires no preparation or sterilization. It serves as an easy-to-use alternative to traditional culture media plates prepared in-house, saving time, labor, and minimizing waste.
- Easy Plate is a dry medium plate developed by Kikkoman Biochemifa (Japan), designed for rapid and convenient microbiological testing. Among them, Easy Plate AC-R is a specialized product for detecting total aerobic bacteria (Aerobic Count – AC), delivering results within only 24 hours.
- Easy Plate AC-R contains a specially formulated medium for the cultivation of aerobic bacteria. The pre-prepared plate includes a chemical indicator that produces easily distinguishable red colonies, allowing quick recognition and enumeration of aerobic bacteria within 24±1 hours. Each box contains 100 tests, divided into 4 separate pouches, each with 25 tests. Shelf life is 12 months when unopened and stored at 2–8℃.
- The plate is designed as a dry medium sheet, ready to use immediately without the need for culture media preparation or sterilization.

2. Specifications Easy Plate AC-R
- Product name: Easy Plate AC-R
- Product code: 61979
- Application: Rapid detection of total aerobic bacteria
- Incubation time: 24 ± 1 hours. In some cases, depending on the sample, colony development may not be sufficient after 24 hours. If this occurs, extend incubation beyond 24 hours as needed.
- Incubation temperature: 35 ± 1℃
- Storage conditions (unopened): 2–8℃
- After opening a pouch, fold the opened end at least twice and seal with tape. Store in a refrigerator (2–8℃) and use within 3 months.
- Shelf life: 12 months from the date of manufacture
3. Principle
The principle of Easy Plate AC-R is based on:
- A dry, pre-prepared medium containing specific nutrients for aerobic bacteria.
- When a diluted sample is dropped onto the plate surface, bacteria grow into colonies.
- Colonies exhibit distinct coloration/features, making enumeration and bacterial density determination easy.
- With improved technology, AC-R enables result reading in just 24 hours, faster than traditional methods
- Colonies turn red, allowing clear observation and counting even in the presence of food residues or colored samples.
- Reducing the spreading of colonies of Bacillus spp.: colonies of Bacillus spp. that can easily spread on conventional agar media but spreading is controlled on Easy Plate.

- High correlation with the plate count agar in various foods.

* Plate Count Interpretation
- Count all red colonies regardless of size or intensity.
- The appropriate number of colonies is between 1 and 250.
+ In certain cases, depending on the sample, colony growth may be insufficient after 24 hours.
+ If this occurs, please extend the incubation period beyond 24 hours as necessary.
4. Benefits
- Rapid: Results in just 24 hours compared to 48–72 hours with conventional methods.
- Convenient: No media preparation or sterilization required; easy to use in laboratories or on-site.
- Cost-saving: Reduces expenses and labor compared to traditional pour plate methods.
- Accurate & Reliable: Results are comparable with international standards (ISO, FDA BAM, etc.).
- Space & cost efficient: Each box contains 100 plates, requiring less storage space than conventional agar media.
- Easy to read: Red colonies are easily distinguished, even with food particles or colored backgrounds.
5. Applications
Easy Plate AC-R from Kikkoman is widely applied in microbiological testing across industries:
- Food industry: Enumeration of aerobic bacteria in meat, fish, processed foods, dairy products, confectionery, fruits, vegetables, and seafood.
- Beverage & drinking water industry: Detection of bacteria in purified water, mineral water, bottled water.
- Cosmetics & pharmaceuticals: Evaluation of microbial contamination in products and raw materials.
- Environmental hygiene testing: Assessment of air quality, production surfaces, and processing equipment in factories.
- QC/QA laboratories: Routine quality control testing in production and processing facilities.
7. Examples
* Strains


* Foods
- Incubation conditions: 35℃, 24 hours (Diluent: phosphate buffered saline)
- These colorings are for example only.
Pacific Science Technology Euquipment Co.,LTD is the official distributor of Kikkoman products in Vietnam. For quotations and detailed product information, please contact us.







